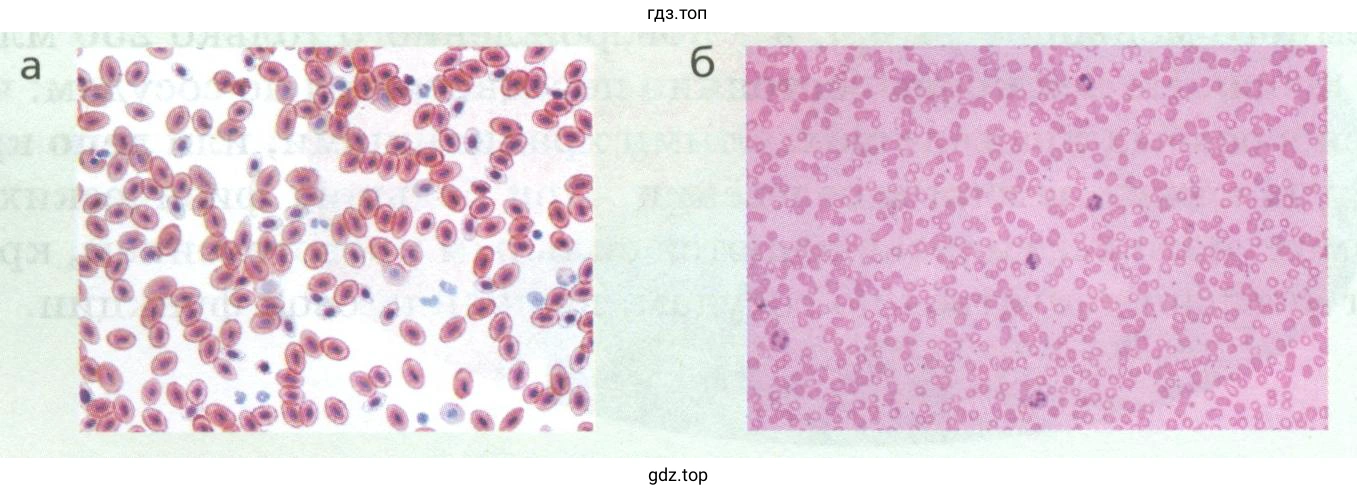

Страница 100 - гдз по биологии 9 класс учебник Пасечник, Каменский

Авторы: Пасечник В. В., Каменский А. А., Швецов Г. Г., Гапонюк З. Г.
Тип: Учебник
Серия: линия жизни
Издательство: Просвещение
Год издания: 2023 - 2025
Уровень обучения: базовый
Цвет обложки: белый, розовый с ракушкой
ISBN: 978-5-09-102246-9 (2023), 978-5-09-112163-6 (2024)
Допущено Министерством просвещения Российской Федерации
Популярные ГДЗ в 9 классе
Cтраница 100

№1 (с. 100)
Условие. №1 (с. 100)
скриншот условия

Каков состав крови человека?
Решение. №1 (с. 100)
скриншот решения

Кровь на 55–60 % состоит из плазмы и на 40–45 % – из форменных элементов
№2 (с. 100)
Условие. №2 (с. 100)
скриншот условия

Что такое плазма крови, каков её состав и функции?
Решение. №2 (с. 100)
скриншот решения

Плазма – это жидкая часть крови, её межклеточное вещество. Она на 90 % состоит из воды, а также включает в себя целый ряд веществ: белки, жиры, сахара, минеральные соли. Часть этих веществ – питательные вещества, переносимые кровью к различным органам. У белков плазмы крови многообразные функции. Одни из них участвуют в свёртывании крови, другие отвечают за связывание болезнетворных микроорганизмов или чужеродных белков, проникших в кровь извне.
№3 (с. 100)
Условие. №3 (с. 100)
скриншот условия

Какое значение для поддержания гомеостаза имеет депо крови?
Решение. №3 (с. 100)
скриншот решения


Значение кровяного депо заключается в возможности быстрого увеличения объема циркулирующей крови, необходимой для обеспечения потребностей организма в данный момент. При отсутствии кровяного депо даже незначительное изменение емкости сосудистой системы приводило бы к резкому снижению притока крови к сердцу и падению артериального давления.
№4 (с. 100)
Условие. №4 (с. 100)
скриншот условия

Рассмотрите рисунок 50. Установите взаимосвязь между строением форменных элементов крови и выполняемыми функциями.
Решение. №4 (с. 100)
скриншот решения

Основная функция эритроцитов – перенос кислорода и углекислого газа. Имея двояковогнутую форму, эритроциты увеличивают общую поверхность, приближают внутреннее содержимое клетки ближе к поверхности, а значит способны как можно больше связать и переправить кислорода или углекислого газа.
Одни виды лейкоцитов вырабатывают особые белки, которые распознают и связывают чужеродные агенты (бактерии, простейшие, грибы), и химические соединения. Эти белки называют антителами. Связанные антителами вредоносные частицы не могут проникнуть в ткани человека и становятся безвредными.
Другие виды лейкоцитов способны к захвату и уничтожению чужеродных частиц, молекул и клеток, проникших в кровь, – фагоцитозу. Кроме того, они могут распознавать и уничтожать раковые и старые, отмирающие клетки.
Тромбоциты представляют собой кровяные пластинки, которые учувствуют в процессе свертывания крови.
№1 (с. 100)
Условие. №1 (с. 100)
скриншот условия

Почему кровь считают символом жизни?
Решение. №1 (с. 100)
скриншот решения

От количества и качества крови зависит состояние организма человека и его жизнь. Поэтому кровь считают символом жизни.
№2 (с. 100)
Условие. №2 (с. 100)
скриншот условия

Почему организму важно поддерживать относительное постоянство внутренней среды?
Решение. №2 (с. 100)
скриншот решения

Постоянство внутренней среды важно для организма, потому что поддержание стабильных условий позволяет клеткам функционировать оптимально. Изменения во внутренней среде могут нарушить нормальное функционирование организма и привести к различным заболеваниям и патологиям.
Моя лаборатория (с. 100)
Условие. Моя лаборатория (с. 100)
скриншот условия


Моя лаборатория
ИССЛЕДУЙТЕ
Изучение микроскопического строения крови человека и лягушки (сравнение)
Цель работы: выяснить особенности (сравнить) строения крови человека и лягушки.
Материалы и оборудование: готовые микропрепараты крови лягушки и человека.
Ход работы
- Рассмотрите препараты крови человека и лягушки. Обратите внимание на форму эритроцитов при рассматривании их сверху и сбоку. Одинакова ли она у человека и лягушки? Подумайте, почему при рассматривании под световым микроскопом эритроциты крови человека в средней части слегка просвечивают.
- Зарисуйте в одном масштабе по 2—3 эритроцита из каждого препарата крови и один лейкоцит из препарата крови человека.
- Найдите черты сходства эритроцитов крови человека и лягушки. Сравните лейкоциты и эритроциты крови человека. В чём их различия?
- Сделайте выводы. Ответьте на вопрос: чья кровь, человека или лягушки, перенесёт в единицу времени больше кислорода и почему? Все ответы и сделанные вами выводы запишите в тетрадь.
ДЛЯ ЛЮБОЗНАТЕЛЬНЫХ
Фагоцитоз. Явление фагоцитоза было открыто великим русским микробиологом Ильёй Ильичом Мечниковым. Именно он обнаружил, что некоторые лейкоциты способны двигаться, подобно амёбам, и захватывать чужеродные частицы в крови. Эти клетки И. И. Мечников назвал фагоцитами, т. е. пожирателями, а открытое явление — фагоцитозом.
Анализ крови и его значение для диагностики состояния организма. Для правильной диагностики заболеваний, оценки состояния организма человека проводят анализ крови. Рассмотрим, что показывает анализ крови на примере наиболее часто назначаемых исследований — общего анализа крови и биохимического анализа крови.
Общий (клинический) анализ крови (ОАК) — наиболее часто используемое исследование, применяемое для диагностики многих заболеваний. Его применяют во всех областях медицины для диагностирования, контроля течения болезней, профилактической оценки состояния организма. В ходе данного анализа определяется много показателей крови, каждый из которых указывает на определённые нарушения работы организма. ОАК позволяет оценить содержание гемоглобина в крови, количество эритроцитов, цветовой показатель, количество тромбоцитов, лейкоцитов и их виды (лейкограмму). Клинический анализ крови также позволяет узнать скорость оседания эритроцитов (СОЭ) — важный показатель, указывающий на воспалительный процесс в организме.
С помощью данного исследования врач может выявить следующие проблемы в организме: анемию (малокровие); воспалительные процессы разной природы; инфекционные заболевания; злокачественные заболевания крови; нарушения свёртываемости крови; наличие аллергических реакций.
С помощью биохимического анализа крови врач определяет состояние и функционирование органов и систем человека, недостаток витаминов и микроэлементов. Существует более 40 показателей данного исследования крови. Каждому пациенту врач назначает исследование тех показателей биохимии крови, которые необходимы для диагностирования определённого заболевания. Наиболее часто определяются следующие характеристики биохимического анализа: общий белок; глюкоза; билирубин и др.
Решение. Моя лаборатория (с. 100)
скриншот решения


Моя лаборатория
ИССЛЕДУЙТЕ
Изучение микроскопического строения крови человека и лягушки (сравнение)
Цель работы: выяснить особенности (сравнить) строения крови человека и лягушки.
Материалы и оборудование: готовые микропрепараты крови лягушки и человека.
Ход работы
1. Рассмотрите препараты крови человека и лягушки. Обратите внимание на форму эритроцитов при рассматривании их сверху и сбоку. Одинакова ли она у человека и лягушки? Подумайте, почему при рассматривании под световым микроскопом эритроциты крови человека в средней части слегка просвечивают.
Эритроциты человека характеризуются двояковогнутой формой, красной окраской и имеют размеры семь-восемь мкм. Продолжительность их жизни варьирует в пределах ста двадцати дней. Красный цвет клетки эритроцита обусловлен гемоглобином, который является основной частью эритроцита.
Эритроциты лягушки – это изолированные клетки правильной овальной формы с гомогенной цитоплазмой интенсивно розового цвета. В центре клетки расположено клеточное ядро, имеющее вытянутую овальную форму.
2. Зарисуйте в одном масштабе по 2–3 эритроцита из каждого препарата крови и один лейкоцит из препарата крови человека.

3. Найдите черты сходства эритроцитов крови человека и лягушки. Сравните лейкоциты и эритроциты крови человека. В чём их различия?
Эритроциты человека не имеют ядра. Их форма представляет собой двояковогнутый диск.
Эритроциты лягушки имеют ядро, их форма овальная.
Черты сходства эритроцитов человека и лягушки:
- красный цвет;
- округлая форма.
4. Сделайте выводы. Ответьте на чья кровь, человека или лягушки, перенесёт в единицу времени больше кислорода и почему? Все ответы и сделанные вами выводы запишите в тетрадь.
Эритроциты человека переносят больше кислорода, чем эритроциты лягушки. Это объясняется, с одной стороны, тем, что эритроцит человека меньше по размерам, чем эритроцит лягушки, и поэтому быстрее переносятся током крови. С другой стороны, утратив ядро, эритроциты человека приобрели двояковогнутую форму, что значительно увеличило их поверхность и позволило одновременно переносить большое количество молекул кислорода.
Помогло решение? Оставьте отзыв в комментариях ниже.